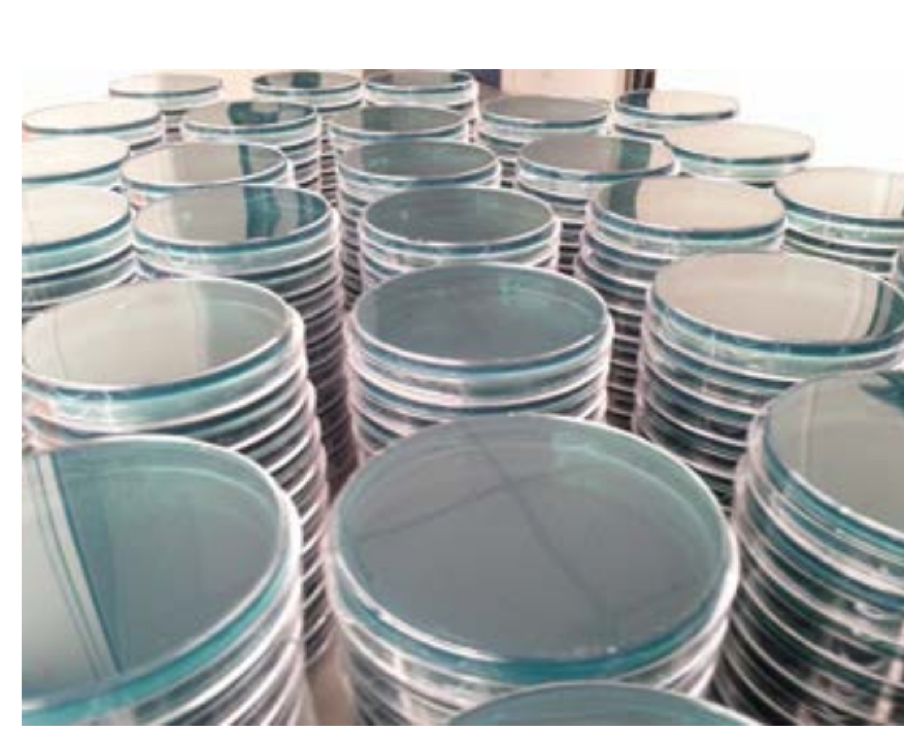

Showing 1681 to 1695 of 2374 results


A Computer System for Automated Reasoning to find implicit information in Natural Language Sentences
Innovative Products and Technologies Langsoft

Multilevel Active-Clamped Electrical Energy Converter
Patents for licensing Universitat Politècnica de Catalunya - UPC

New device for laboratory animal telemetry
Patents for licensing Universitat Politècnica de Catalunya - UPC
New antimicrobial and anti-tumor treatment
Patents for licensing Universitat de València
New method for the production of metallic oxides with spinel structure
Patents for licensing Universitat de València

New dendrimer as a contrast agent in magnetic resonance imaging (MRI)
Patents for licensing ICMAB-CSIC

Device to determine the food shelf-life
Patents for licensing Consejo Superior de Investigaciones Científicas

Hybrid diffractive/refractive optics simulator: method and device
Patents for licensing Universitat Politècnica de Catalunya - UPC

Balance Belt - A safety and rehabilitation aid for training of standing up, balancing and walking
Innovative Products and Technologies University Hospital Hradec Králové

DRooTES: Double Rooted Trailing Edge Serrations for quiet blades
Innovative Products and Technologies Brunel University London

Regenerative medicine for drug screening
Innovative Products and Technologies IDIBELL

Fabrication of tips for scanning probe microscopy with enhanced resolution
Patents for licensing Consejo Superior de Investigaciones Científicas

Technology and proccesses for chemical synthesis
Research Services and Capabilities FUNDITEC

A resilient and user-friendly CAPTCHA
Patents for licensing Unismart - University of Padua Foundation
